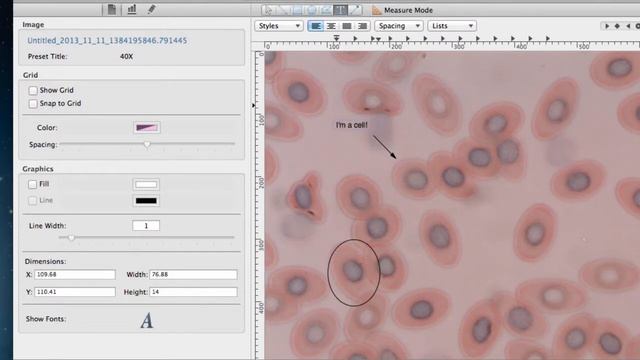
INFINITY ANALYZE for Mac Part 4: Editing Images смотреть онлайн

Автор: Passionate Apple TV Страница 8

「最後の雨」RYUTO KAZUHARA Billboard Live 2023

Dapple Effect

Mr. Brightside - The Killers (Boyce Avenue acoustic cover) on Spotify & Apple

MI PREPARO CON VOI: Flat Out Fabolous!

Colin McRae Rally 2 | Italy | stage 3

Ella - Alizee

SOFT GLAM WITH THE CHEAPEST MAKEUP EVER!!!!!!

Working Lego Mac-10 SMG (full-semi auto). by Kevin183

💻 SHOULD YOU BUY an M1 MacBook Air or WAIT for M2?

Project 2 Tutorial

CAT 11_Spreadsheets_ Open Office Lesson 22 Print Options

Grooveshark - Listen to Free Music Online Without Downloading

Yugior Forbidden Memories cheat engine part 1

AirPods Pro Оригинальныe как проверить ?

07 04 2023=MAÇ 21 30 KAMERA 1

Часы Apple Watch 9 копия 2024 года

MacUpdate Desktop 6 Screencast
INFINITY ANALYZE for Mac Part 4: Editing Images
![playboi carti - r.i.p. (updated instrumental remake) [garageband ios] смотреть онлайн](https://pic.rutubelist.ru/video/2024-10-19/82/b4/82b40fd31495d6796ab86c0b681ca4a1.jpg?size=m)
playboi carti - r.i.p. (updated instrumental remake) [garageband ios]

Come scaricare programmi a pagamento gratis

Deleting and retrieving images and patients in Planmeca Romexis

How to Install and Run Apps on Mac From External Drive.

Mantric Jam (Moog Mother 32 + Native Instruments West Africa)

Plug-ins & EQ - GarageBand for iOS (iPhone/iPad) Quick Tip
За каждым успешным каналом стоит личность, идея и сотни часов кропотливого труда. Если вы здесь, значит, автор «Passionate Apple TV» уже сумел зацепить ваше внимание своим уникальным стилем или подачей. А мы на RUVIDEO позаботились о том, чтобы вы могли изучить весь архив его работ в максимально комфортных условиях — без лишней суеты и преград.
Почему за работами канала «Passionate Apple TV» так интересно наблюдать? Всё просто: это честный контент, который находит отклик в сердцах зрителей. На нашем ресурсе вы можете смотреть онлайн все видео любимого автора бесплатно и в хорошем качестве. Нам важно, чтобы вы видели каждую деталь и слышали каждый нюанс, поэтому мы используем только стабильные плееры из открытых источников Rutube.
Следите за новинками канала, пересматривайте старые шедевры и открывайте для себя новые грани творчества «Passionate Apple TV». Мы постоянно обновляем ленту, чтобы у вас под рукой всегда были самые свежие выпуски. Никаких сложных регистраций — только вы и творчество, которое вдохновляет. Приятного вам путешествия по миру авторского контента на RUVIDEO!
Видео взято из открытых источников Rutube. Если вы правообладатель, обратитесь к первоисточнику.